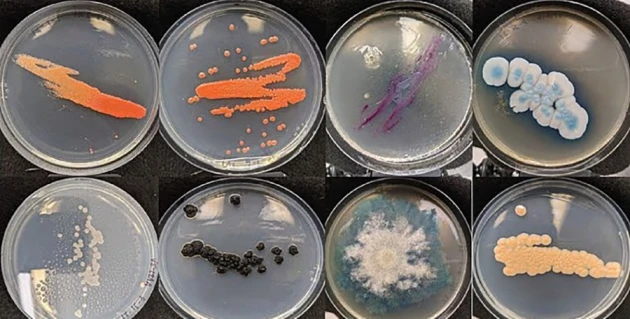

Το ηλεκτρονικό τσιγάρο συχνά προβάλλεται ως μια πιο «καθαρή» και υγιεινή εναλλακτική του καπνίσματος.
Ωστόσο, νέα μελέτη δείχνει ότι οι ατμιστές μπορεί να εισπνέουν πολύ περισσότερα από μια δόση νικοτίνης κάθε φορά που τραβούν ρουφηξιά από το ηλεκτρονικό τους τσιγάρο.
Επιστήμονες από το Πανεπιστήμιο της Φλόριντα διαπίστωσαν ότι τα επιστόμια των ηλεκτρονικών τσιγάρων είναι γεμάτα με βλαβερούς μύκητες.
Λόγω του κλειστού πλαστικού σχεδιασμού τους και της συχνής θέρμανσης από τη χρήση, τα ηλεκτρονικά τσιγάρα προσφέρουν ιδανικό περιβάλλον για την ανάπτυξη μυκήτων.
Η κατάσταση επιδεινώνεται ακόμη περισσότερο από το γεγονός ότι η πλειονότητα των χρηστών παραδέχθηκε πως δεν καθαρίζει ποτέ τη συσκευή της.
Αν και λίγα ηλεκτρονικά τσιγάρα φέρουν βακτήρια, περισσότερα από τα μισά μιας χρήσης που εξετάστηκαν βρέθηκαν «εκτεταμένες αποικίες» από μύκητες.
Από αυτούς, πάνω από το 80% ήταν ικανοί να προκαλέσουν προβλήματα υγείας, περιλαμβανομένων παθογόνων που οδηγούν σε πνευμονικές νόσους, όπως η χρόνια βρογχίτιδα.
Ο συχνότερος μικροοργανισμός που εντοπίστηκε είναι ο μύκητας Cystobasidium minutum, ο οποίος μπορεί να προκαλέσει λοιμώξεις του αίματος σε άτομα με εξασθενημένο ανοσοποιητικό.
Η έρευνα αποκάλυψε ότι το επιστόμιο ενός ηλεκτρονικού τσιγάρου μπορεί να «φιλοξενεί» έως και 35 διαφορετικά είδη μυκήτων, τα περισσότερα εκ των οποίων είναι δυνητικά επικίνδυνα.
Οι ερευνητές πήραν δείγματα από 25 επιστόμια ηλεκτρονικών τσιγάρων και τα καλλιέργησαν, αποκαλύπτοντας την αηδιαστική ποσότητα μυκήτων που ζουν μέσα τους (εικόνα). Φωτογραφία Katy Deitz/ πανεπιστήμιο Φλόριντα.
Τα δείγματα συγκρίθηκαν με καλλιέργειες από τα στόματα των συμμετεχόντων και αποδείχθηκε ότι οι παθογόνοι οργανισμοί δεν προέρχονταν από τους ίδιους τους χρήστες, αλλά από το περιβάλλον.
Κάποιοι μύκητες ενδέχεται να προέρχονται από τον αέρα, τα χέρια ή τη σκόνη γύρω μας, ενώ άλλοι ίσως υπήρχαν ήδη στα υγρά του ατμίσματος πριν την αγορά.
Ο καθηγητής Τζέισον Σμιθ, του Ινστιτούτου Αναδυόμενων Παθογόνων, ανέφερε: «Τα υπολείμματα που μένουν μέσα στη συσκευή ίσως αποτελούν πηγή τροφής για την ανάπτυξη μούχλας».
Στο προδημοσιευμένο άρθρο τους, οι ερευνητές υποστηρίζουν ότι η «μυκητιακή μόλυνση των ηλεκτρονικών τσιγάρων» συμβάλλει στην εμφάνιση της Χρόνιας Αποφρακτικής Πνευμονοπάθειας (ΧΑΠ).
Η νόσος αυτή περιλαμβάνει μια ομάδα πνευμονικών παθήσεων που προκαλούν δυσκολία στην αναπνοή, δύσπνοια και επίμονο βήχα.
Στην έρευνα, το ένα τρίτο των συμμετεχόντων δήλωσε ότι παρουσίαζε αναπνευστικά συμπτώματα, όπως βήχα.
Για να κατανοήσουν καλύτερα τις επιπτώσεις, οι επιστήμονες έκαναν πειράματα με ποντίκια, τα οποία εισέπνευσαν το συχνότερο παθογόνο, το C. minutum.

Οι ερευνητές έκαναν πειράματα με ποντίκια, τα οποία εισέπνευσαν τον πιο κοινό μύκητα που βρέθηκε στα ηλεκτρονικά τσιγάρα, τον Cystobasidium minutum, προκειμένου να διαπιστώσουν πώς η εισπνοή αυτού του μύκητα επηρεάζει τους πνεύμονες. Οι εικόνες B, F, G και H δείχνουν τον πνευμονικό ιστό των επηρεασμένων ποντικιών, αποκαλύπτοντας την ανάπτυξη χρόνιας βρογχίτιδας. Φωτογραφία Katy Deitz.
Ο επικεφαλής, καθηγητής Μπόρνα Μεχράντ, εξήγησε: «Διαπιστώσαμε ότι ο μύκητας που βρέθηκε πιο συχνά στα δείγματα προκάλεσε χαρακτηριστικά χρόνιας βρογχίτιδας στα ποντίκια».
Οι ερευνητές καλούν τους χρήστες να καθαρίζουν συχνά τα επιστόμια για να αποφύγουν τη συσσώρευση μυκήτων, αν και τονίζουν ότι δεν υπάρχουν ακόμη επαρκή στοιχεία για να αποδειχθεί ότι η ποσότητα είναι αρκετή ώστε να αρρωστήσει η πλειοψηφία των χρηστών.
Τι είναι το ηλεκτρονικό τσιγάρο και πώς διαφέρει από το κανονικό κάπνισμα;
Το ηλεκτρονικό τσιγάρο είναι μια συσκευή που επιτρέπει την εισπνοή νικοτίνης μέσω της θέρμανσης υγρού που περιέχει νικοτίνη, προπυλενογλυκόλη και αρωματικές ουσίες.
Επειδή δεν υπάρχει καύση, δεν παράγεται καπνός όπως στο παραδοσιακό τσιγάρο.
Αν και θεωρούνται λιγότερο βλαβερά από τα συμβατικά τσιγάρα, όλο και περισσότερες μελέτες επισημαίνουν κινδύνους για την υγεία.
Δεν παράγουν πίσσα ή μονοξείδιο του άνθρακα, αλλά οι ατμοί περιέχουν βλαβερές χημικές ουσίες.
Η νικοτίνη, εξαιρετικά εθιστική ουσία, καθιστά δύσκολη τη διακοπή.
Στη Βρετανία σχεδόν 3 εκατομμύρια άτομα χρησιμοποιούν ηλεκτρονικά τσιγάρα, ενώ στις ΗΠΑ οι χρήστες ξεπερνούν τα 9 εκατομμύρια.
Τύποι ηλεκτρονικών τσιγάρων:
- Τυπικό ηλεκτρονικό τσιγάρο
- Συσκευή με μπαταρία που περιέχει υγρό νικοτίνης.
- Εξατμίζει το αρωματισμένο υγρό νικοτίνης.
- Juul
- Παρόμοιο με τα κανονικά ηλεκτρονικά τσιγάρα, αλλά με πιο κομψό σχεδιασμό και, στις ΗΠΑ, με υψηλότερη περιεκτικότητα νικοτίνης (στην ΕΕ και ΗΒ περιορίζεται στα 20 mg/ml).
- Χάρη στα «νικοτινικά άλατα», μια κάψουλα ισοδυναμεί με την ποσότητα νικοτίνης ενός πακέτου τσιγάρων.
- Αποτελείται από τη συσκευή (μπαταρία και έλεγχο θερμοκρασίας) και την κάψουλα υγρού.
- IQOS (Philip Morris)
- Συσκευή σε μορφή στυλό, φορτίζεται όπως ένα iPod.
- Θερμαίνει τον καπνό αντί να τον καίει (στους 350°C αντί για 600°C).
- Η εταιρεία υποστηρίζει ότι μειώνει την έκθεση των χρηστών σε καρκινογόνες ουσίες.
Πηγή: www.neakriti.gr
